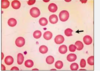

State the name of this symptom of Crohn’s [1]

Pyostomatitis vegetans: an inflammatory stomatitis

What sign of Crohn’s Disease are the arrows pointing to? [1]

Rosehorn ulcer

Describe the blood tests used to investigate Crohns [5]
Anaemia:
- is common and may be normocytic, normochromic of chronic disease.
- However, deficiency of iron/folate may occur.
- Despite common terminal ileum involvement, megaloblastic anaemia due to B12 deficiency is unusual
Raised ESR and CRP; raised WCC and platelets
Hypoalbuminemia is present in severe disease
Liver biochemistry may be abnormal
Serological testing; p-ANCA would be negative (ANCAs are more commonly found in ulcerative colitis)
Extra-intestinal manifestations (EIM) refer to the collection of clinical features that occur outside the gastrointestinal tract within CD.
What is the most common EIM? [1]
Describe this EIM of CD [2]
Musculoskeletal disease:
Two forms of arthritis are seen, type 1 and type 2.
- Type 1 is a pauciarticular peripheral arthritis related to intestinal disease activity.
- Type 2 is a polyarticular peripheral arthritis independent of intestinal disease activity.
Describe the management plan to induce remisison of Crohns in mild-moderate [2] and moderate-severe patients [3]
mild-to-moderate CD:
- a course of exclusive enteral nutrition (EEN) can be considered over an 8 week period
- oral prednisolone (40mg/d for 1 week, then 5mg every week for 7 weeks)
moderate-to-severe CD:
- IV steroids: IV hydrocortisone or methylprednisilone
- there should be consideration of early introduction of immunosuppressive therapy: azathioprine or methotrexate alongside budesonide, prednisilone or hydrocortisone (These medications help with long-term control, but are not useful at initially inducing remission, which is why they are combined with steroids)
- - Biologicals: inflximab, adalimubab (anti-TNF); Vedolizumab (anti-integrins); Ustekinumab (anti-IL12/13)

A patient has moved onto maintence therapy for Crohns.
Which one of the following drugs is the most appropriate to prescribe?
Azathioprine
Budesonide
Mesalazine
Methotrexate
Oral glucocorticoids
A patient has moved onto maintence therapy for Crohns.
Which one of the following drugs is the most appropriate to prescribe?
Azathioprine
Budesonide
Mesalazine
Methotrexate
Oral glucocorticoids
A 33-year-old man was admitted to the surgical ward due to an exacerbation of Crohn’s disease. He presented with a perianal abscess that has been surgically drained. An MRI confirms a complex perianal fistula.
In addition to an antibiotic and a biologic, what other management would be indicated?
Lidocaine gel
Rectal mesalazine
Seton placement
Surgical resection
Topical glyceryl trinitrate
A 33-year-old man was admitted to the surgical ward due to an exacerbation of Crohn’s disease. He presented with a perianal abscess that has been surgically drained. An MRI confirms a complex perianal fistula.
In addition to an antibiotic and a biologic, what other management would be indicated?
Seton placement
A seton is a piece of surgical thread that is run through the fistula to allow continuous drainage while the fistula is healing. This ensures that the fistula doesn’t heal containing pus within, which would result in further abscess formation.
If a Crohn’s patient has had an ileocacel resection, why may diarrhoea occur? [1]
Name a drug that can treat this [1]
The patient most likely has a diagnosis of bile acid malabsorption as a complication of the ileocecal resection.
Treat using: Cholestyramine - bile acid sequestrant with the potential to control diarrhoea induced by bile acid malabsorption.
Which drugs are first line to induce remission in CD? [3]
glucocorticoids:
* prednisolone; hydrocortisone oral, topical or intravenous) are generally used to induce remission.
* Budesonide is an alternative in a subgroup of patients
Inducing Remission:
Which drugs are used as second-line to glucorticosteroids for CD? [2]
Which drugs may be added alongside ^? [2]
What is important to note about this^ [1]
5-ASA drugs (e.g. mesalazine) are used second-line to glucocorticoids but are not as effective
azathioprine or mercaptopurine may be used as an add-on medication to induce remission but is not used as monotherapy.
Inducing Remission:
Which drug is used to treat refractory CD? [1]
infliximab .
Inducing Remission:
Describe the management plan for treating fistulaes [3]
patients with symptomatic perianal fistulae are usually given oral metronidazole
(+)
Infliximab
(+)
draining seton
a seton is a piece of surgical thread that’s left in the fistula for several weeks to keep it open. This is useful because persisting fistula tracks after premature skin closure predispose to abscess formation
Maintaining remission
Which drugs are used as first line maintainene for CD? [2]
What is second line? [1]
azathioprine or mercaptopurine is used first-line to maintain remission
methotrexate is used second-line
Fistulas
In a patient with CD fistulas, what drugs are used if:
Symptomatic peri-anal fisutlae? [1]
To help close and maintain perianal fistulas? [1]
For complex fistulae? [1]
- patients with symptomatic perianal fistulae are usually given oral metronidazole
- anti-TNF agents such as infliximab may also be effective in closing and maintaining closure of perianal fistulas
- a draining seton is used for complex fistulae
What treatment is given for Crohn’s patients who develop a perianal fistula? [1]
Oral metronidazole
A 22-year-old lady has a long history of severe perianal Crohns disease with multiple fistulae. She is keen to avoid a stoma. However, she has progressive disease and multiple episodes of rectal bleeding. A colonoscopy shows rectal disease only and a small bowel study shows no involvement with Crohns.
What is the best surgical option? [1]
Proctectomy
Define short bowel syndrome [3]
Short bowel syndrome (SBS) refers to a condition wherein substantial portions of the small intestine are absent, either congenitally or due to resection
Typically, less than 200 cm of residual short bowel is present.
This results in a loss of surface area for fluid, nutrient, and medication absorption, causing an inability to maintain protein-energy, fluid, electrolyte, or micro-nutrient balance when ingesting a conventionally accepted, normal diet.
Terminal ileal Crohns remains the commonest disease site. How might patients be treated surgically? [1]

Terminal ileal Crohns remains the commonest disease site and these patients may be treated with limited ileocaecal resections.
What pathology may terminal ileal Crohns lead to? [1]
Terminal ileal Crohns may affect enterohepatic bile salt recycling and increase the risk of gallstones.
Descricbe characteristic findings of colonoscopy in UC patients [4]
- rectal involvement
- continuous uniform involvement
- loss of vascular marking
- diffuse erythema
- mucosal granularity
How can you differentiate between UC and CD via endoscopy? [6]
UC:
- continuous inflammation:
- there is no areas of normal mucosa in-between areas of inflammation
- diffuse erythema
- friability, granularity
- loss of vascular pattern in the colon.
CD:
- incontinuous areas of inflammation normal bowel in-between inflammatory segments
- deep fissuring ulcers
- “cobblestoned” mucosa are present.

Describe how you differentiate between recent v chronic UC via a histology sample? [1]
Chronic:
- crypt architecture distortion: they look twisted and disorganised

(Zero to finals)
Mild to moderate acute ulcerative colitis is treated with [2]
Severe acute ulcerative colitis is treated with [1]
Other options for severe acute ulcerative colitis include: [3]
Mild to moderate acute ulcerative colitis is treated with:
* Aminosalicylate (e.g., oral or rectal mesalazine) first-line
* Corticosteroids (e.g., oral or rectal prednisolone) second-line
Severe acute ulcerative colitis is treated with:
* Intravenous steroids (e.g., IV hydrocortisone) first-line
Other options for severe acute ulcerative colitis include:
- Intravenous ciclosporin
- Infliximab
- Surgery